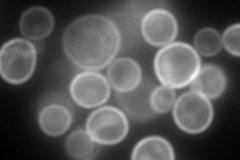
YPR149W

View description
Protein of unknown function; contains transmembrane domains; involved in secretion of proteins that lack classical secretory signal sequences; component of the detergent-insoluble glycolipid-enriched complexes (DIGs)
Localization:
Intensity:
Fold change:
Significance:
-
C’ GFP library in SD

punctate307.9 -
N' NOP1pr-GFP in SD

cell periphery,punctate244.188 -
N' TEF2pr-mCherry in SD
cell periphery,vacuole membrane432.386 -
N' NATIVEpr-GFP in SD

cell periphery,punctate222.331 -
N' TEF2pr-VC and Cyto-VN in SD

cell periphery,punctate50.2712 -
C’ GFP library in SD+DTT

punctate403.041.3No -
C’ GFP library in SD+H2O2

punctate340.171.1No -
C’ GFP library in Starvation Media

punctate845.842.74Yes -
C’ GFP library on the background of Pup2-DaMP

N/A -
C’ GFP library on the background of CCT mutant

N/A0N/AYes
